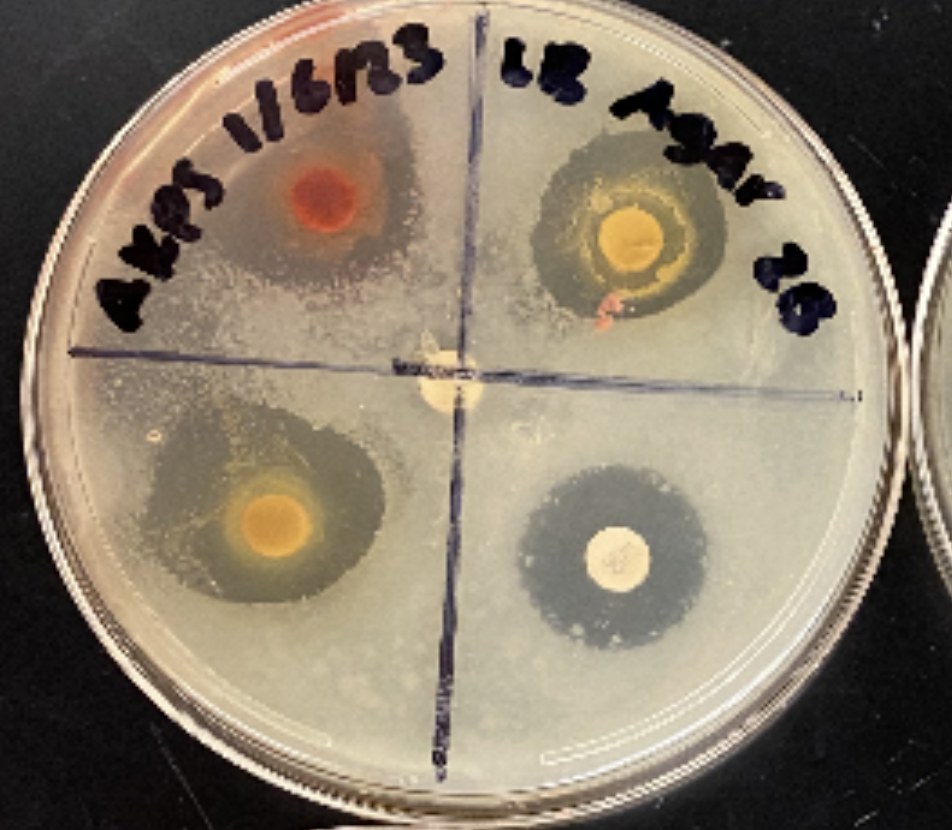

My Research
Ayurvedic Herbs:
Medicine or Voodoo?
Sophomore year, midterms were creeping up on us and our research teacher announced our biggest research project of the year. We had to work with partners and use the techniques we learned in class to research antibacterial properties. Of what you may ask? Well that was up to us.
We looked at all the past examples: foods, soaps, shampoos, chemicals and more. The teacher talked about how she was tired of all the commercial products that the previous classes had chosen. As the last class, we were told that our ideas had to be natural. At first, it was annoying, but looking back, it made for one of the best projects I’ve completed to date. We decided to test the antibacterial properties of various ayurvedic herbs.
Ayurveda is a form of alternative medicine that emphasizes the balancing of the mind-body connection. It attempts to balance the body energies or “doshas”, which are known as Vata, Pitta, and Kapha for motion, metabolism, and growth, respectively. Although Ayurveda is not taught at most of the medical schools and not a mainstream treatment in our world today, its popularity is gaining momentum as people seek natural approaches regarding their health. In ayurveda, it is considered that the imbalance of these three doshas is a cause for mental and physical disorders in individuals. Every individual has a different combination of these three doshas, and the ultimate goal is balance. Ayurveda resorts to herbal medicines and diets, exercises, and yoga to regain this balance.
Many people use Ayurveda for rheumatic pains, depression, and hypothyroidism, amongst others health concerns. For this experiment specifically, we were going to test the antibacterial properties of ayurvedic medicines, so we had to compare them to standard antibiotics. A big concern in today’s world is antibiotic resistance as the rates of prescription increase. Ayurveda's holistic approach, combined with the application of natural remedies, makes it an alternative for patients who seek a different health and wellness approach.
That's where Ayurveda comes in. If they do indeed show antibacterial properties, well then they could be a solid replacement for antibiotics in minor cases. The herbs that we chose Haritaki, which has antibacterial, antioxidant, and antidiabetic properties; Triphala, a mixture of three plants used for working on constipation and blood sugar; and Manjisthadi, which works in blood purification, skin disorder treatment, and detoxification of the liver. The herbs have phytochemicals that fight bacteria and inflammation because they have antibacterial properties.
Infections by Bacillus cereus, a common soil and food pathogen, lead to diseases in the area of gastrointestinal, while kanamycin is an antibiotic used to have an action against an infection caused by Bacillus cereus. So, we chose these two to test the herbs used as a control in the experiment.
All the three extracts—Haritaki, Triphala, and Manjisthadi—showed significant antibacterial activity compared to water. Maximum zone of inhibition was observed in Haritaki at 17.9 mm, followed by Triphala, which does not contain Haritaki in it. However, all the extracts studied efficiently suppressed bacterial growth. Out of these, Haritaki was most effective against Cereus.
The experiment was conducted to compare the antibacterial properties of common herbal medicines in Ayurvedic medicine against a standard antibiotic and analyze their potential for bacterial infection treatment. Overall, the results of the data indicated that while Ayurvedic medicines may not be able to replace modern antibiotics, they can be used to complement them. In our day to day lives, it is clear that Ayurvedic herbs are quite powerful and do indeed have healing properties: they aren’t just voodoo!